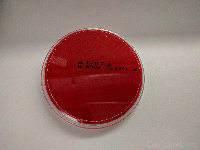
Blood agar
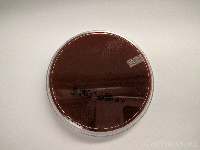
Chocolate agar

Indications to culture a corneal ulcer [1]
- The American Academy of Ophthalmology (AAO) recommends culture if the corneal infiltrate:
- Involves the central cornea
- Involves the deep stroma
- Covers a large area (> 2 mm)
- The AAO also recommends culture for patients with a history or clinical exam that suggests an unusual causative pathogen:
- Fungal organisms
- Amoeba
- Mycobacteria
- Drug-resistant organisms
- History or exam findings suggestive of unusual pathogens include:
- Use of contaminated lens solutions
- Exposure to swimming pools or hot tubs
- Trauma or exposure to vegetable matter
- Immunosuppressed state
- Raised or gray ulcers
- Satellite or multiple lesions
- Feathery edges
- Radial Keratoneuritis
- Descemetocele
| Supplies |
Targeted Organism |
Photo Example |
Plates (2) |
Blood agar |
Aerobic bacterias |
|
Chocolate agar |
Haemophilus,
Neisseria gonorrhea |
|
Tubes (5) |
Pink viral media |
Herpes simplex virus PCR |
 |
Potato dextrose
(slant tube) |
Fungi |
 |
Middlebrook 7H11
(slant tube)
OR
Lowenstein-Jensen
(slant tube) |
Mycobacteria |
 |
Thioglycolate broth |
Anaerobic bacteria |
 |
Tryptan soy broth (TSB) |
Aerobic bacteria |
 |
Slides (2) |
Glass slide 1
Glass slide 2 |
Gram stain
Fungal stain |
 |
Swabs (8) |
Sterile polyester tipped swab (1) |
Viral PCR |
 |
Sterile calcium alginate swabs (7) |
Bacterial and fungal cultures |
 |
Additional Supplies
- Proparacaine drops
- Patient labels for each culture and stain
- Biohazard specimen bags
Swabbing Technique
- Swab the base of the corneal ulcer using gentle pressure with the appropriate swab. There should be enough pressure to indent the cornea slightly. If the cornea is significantly thinned, apply less pressure to avoid perforation. Multiple passes can be made to ensure adequate sampling.
- Remember to avoid the eyelids and eyelashes to prevent contamination of the culture by skin flora.
Streaking Technique
- Container lids should remain on the culture media at all times, both before and after inoculation.
-
- Streak multiple "C" shapes onto the glass slides and agar plates. Gentle pressure should be applied while streaking, but take care not to puncture the agar media.
- Inoculate the agar slants, beginning at the base of the slant, streaking horizontally as you move toward the top of the tube.
Preparation
- Gather the supplies
- Pre-label all media and slides
- Instill topical proparacaine
- Remember to avoid the eyelids and eyelashes while swabbing to avoid contamination. Once unsheathed, the swabs should only contact the corneal ulcer and the medium or glass slide they are inoculating.
Procedure
HSV/viral media inoculation
- Use the dry, sterile, polyester tipped swab to sample the ulcer
- Place the swab deep in the pink viral media
- Snap off the swab tip, discarding the remaining handle
- Close the tube, leaving the swab tip in the tube
Gram and fungal stains
- Dip a calcium alginate swab in the TSB medium
- Sample the corneal ulcer
- Streak multiple "C" shapes across the slide
- Discard the swab
Inoculate the blood and chocolate agar plates
- Dip a fresh, sterile calcium alginate swab into the TSB medium
- Sample the corneal ulcer
- Streak the surface of the blood agar plate, making several isolated "C" shapes without penetrating the agar itself
- Repeat for the chocolate agar plate using a new calcium alginate swab dipped in TSB
Inoculate the two slant cultures (Middlebrook 7H11 and potato dextrose media)
- Dip a fresh, sterile calcium alginate swab into the TSB medium
- Sample the corneal ulcer
- Streak the surface of the slant tube from base to apex
- Repeat for the remaining slant using a new calcium alginate swab dipped in TSB
Inoculate the two broth cultures (Thioglycolate first, and then TSB)
- Dip a fresh, sterile calcium alginate swab into the TSB medium
- Sample the corneal ulcer
- Swirl the calcium alginate swab in the thioglycolate broth
- Discard the swab
- Dip a new, sterile calcium alginate swab into the TSB medium
- Sample the corneal ulcer
- Place the calcium alginate swab back into the TSB medium and swirl, inoculating and contaminating the TSB medium
It is CRITICAL to inoculate the TSB medium last. Contamination of the TSB medium before the other cultures have been inoculated may lead to decreased sensitivity and specificity of the corneal culture.
With all of the specimens adequately labeled and placed in the appropriate biohazard bags, promptly send to your local microbiology lab for analysis.
- Weisenthal R. Basic and Clinic Science Couse: External Disease and Cornea (Section 8). San Francisco: American Academy of Ophthalmology, 2015.
Suggested Citation Format:
Fairbanks AM, Provencher LM, Greiner MA, Sindt C. A Guide to the Corneal Culture. EyeRounds.org. posted September 26, 2016; Available from: https://eyerounds.org/tutorials/cornea-culture/index.htm